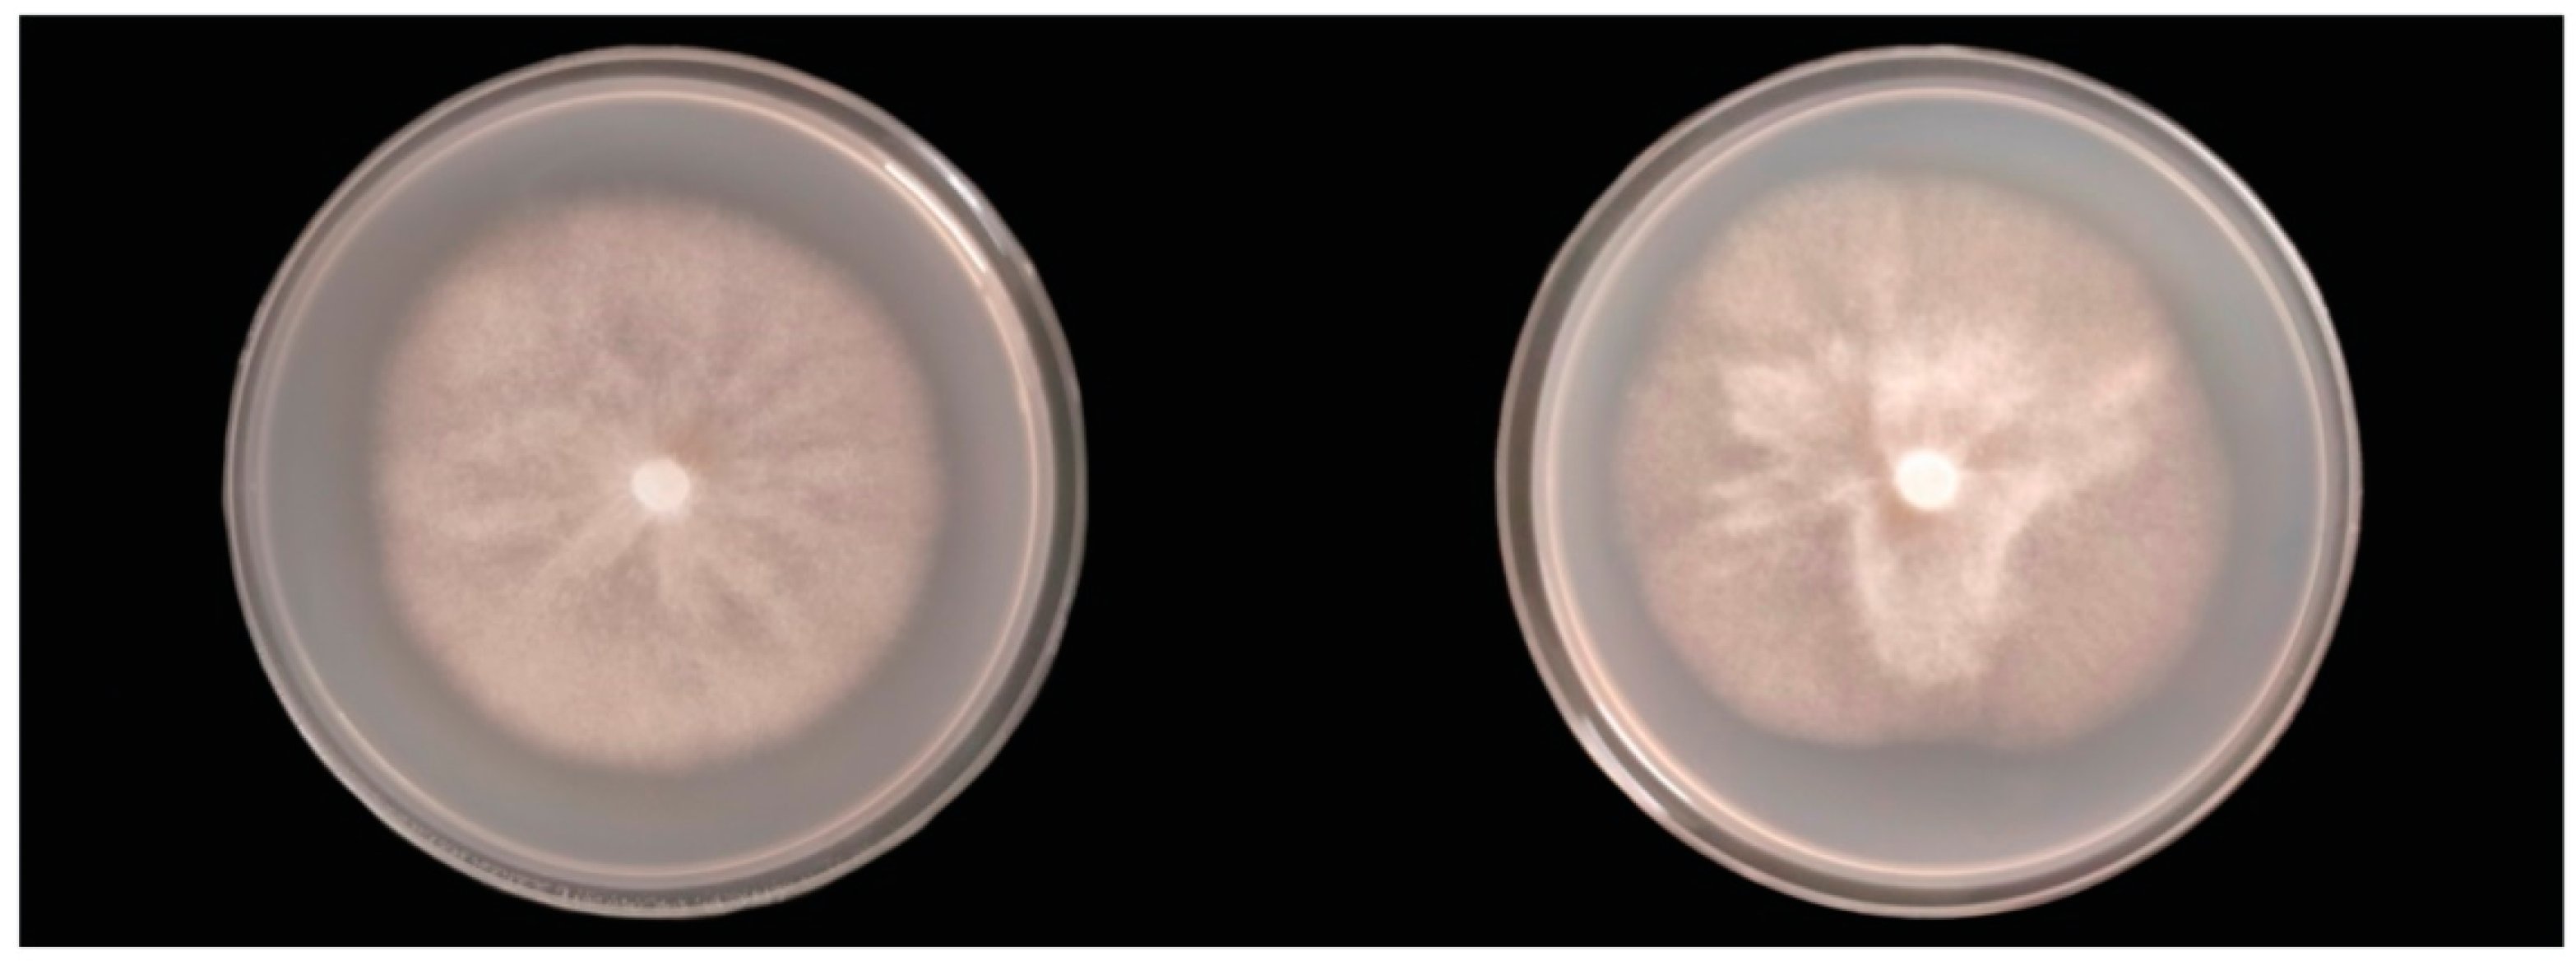

Phytophthora podocarpi sp. nov. from Diseased Needles and Shoots of Podocarpus in New Zealand
Abstract
1. Introduction
2. Materials and Methods
2.1. Sampling
2.2. Detection and Isolation
2.3. DNA Isolation, Amplification, and Sequencing
2.4. Phylogenetic Analysis
2.5. Pathogenicity Studies
2.6. Colony Morphology, Growth Rates, and Cardinal Temperatures
2.7. Morphology of Sexual and Asexual Structures
3. Results
3.1. Sampling and Isolation
3.2. Molecular Phylogenetic Position
3.3. Pathogenicity
3.4. Taxonomy
4. Discussion
5. Conclusions
Supplementary Materials
Author Contributions
Funding
Acknowledgments
Conflicts of Interest
References
- Studholme, D.; McDougal, R.; Sambles, C.; Hansen, E.; Hardy, G.; Grant, M.; Ganley, R.; Williams, N. Genome sequences of six Phytophthora species associated with forests in New Zealand. Genom. Data 2016, 7, 54–56. [Google Scholar] [CrossRef] [PubMed]
- McCarthy, C.G.; Fitzpatrick, D.A. Phylogenomic reconstruction of the oomycete phylogeny derived from 37 genomes. Msphere 2017, 2, e00095-17. [Google Scholar] [CrossRef] [PubMed]
- Bourret, T.B.; Choudhury, R.A.; Mehl, H.K.; Blomquist, C.L.; McRoberts, N.; Rizzo, D.M. Multiple origins of downy mildews and mito-nuclear discordance within the paraphyletic genus Phytophthora. PLoS ONE 2018, 13, e0192502. [Google Scholar] [CrossRef] [PubMed]
- Burgess, T.I.; Wingfield, M.J. Pathogens on the Move: A 100-Year Global Experiment with Planted Eucalypts. Bioscience 2016, 67, 14–25. [Google Scholar] [CrossRef]
- McTaggart, A.R.; van der Nest, M.A.; Steenkamp, E.T.; Roux, J.; Slippers, B.; Shuey, L.S.; Wingfield, M.J.; Drenth, A. Fungal Genomics Challenges the Dogma of Name-Based Biosecurity. PLoS Pathog. 2016, 12, e1005475. [Google Scholar] [CrossRef]
- Erwin, D.C.; Ribeiro, O.K. Phytophthora Diseases Worldwide; APS Press: St. Paul, MN, USA, 1996. [Google Scholar]
- Cooke, D.E.; Drenth, A.; Duncan, J.M.; Wagels, G.; Brasier, C.M. A molecular phylogeny of Phytophthora and related oomycetes. Fungal Genet. Biol. 2000, 30, 17–32. [Google Scholar] [CrossRef]
- Schena, L.; Duncan, J.M.; Cooke, D.E.L. Development and application of a PCR-based ‘molecular tool box’ for the identification of Phytophthora species damaging forests and natural ecosystems. Plant Pathol. 2008, 57, 64–75. [Google Scholar] [CrossRef]
- McDougal, R.L.; Cunningham, L.; Hunter, S.; Caird, A.; Flint, H.; Lewis, A.; Ganley, R.J. Molecular detection of Phytophthora pluvialis, the causal agent of red needle cast in Pinus radiata. J. Microbiol. Methods 2021, 189, 106299. [Google Scholar] [CrossRef]
- Blair, J.E.; Coffey, M.D.; Park, S.-Y.; Geiser, D.M.; Kang, S. A multi-locus phylogeny for Phytophthora utilizing markers derived from complete genome sequences. Fungal Genet. Biol. 2008, 45, 266–277. [Google Scholar] [CrossRef]
- Thompson, J.D.; Higgins, D.G.; Gibson, T.J. CLUSTAL W: Improving the sensitivity of progressive multiple sequence alignment through sequence weighting, position-specific gap penalties and weight matrix choice. Nucleic Acids Res. 1994, 22, 4673–4680. [Google Scholar] [CrossRef]
- Kearse, M.; Moir, R.; Wilson, A.; Stones-Havas, S.; Cheung, M.; Sturrock, S.; Buxton, S.; Cooper, A.; Markowitz, S.; Duran, C.; et al. Geneious Basic: An integrated and extendable desktop software platform for the organization and analysis of sequence data. Bioinformatics 2012, 28, 1647–1649. [Google Scholar] [CrossRef] [PubMed]
- Nylander, J. MrModeltest v2; Uppsala University, Evolutionary Biology Centre: Uppsala, Sweden, 2004. [Google Scholar]
- Akaike, H. A new look at the statistical model identification. IEEE Trans. Autom. Control. 1974, 19, 716–723. [Google Scholar] [CrossRef]
- Ronquist, F.; Teslenko, M.; van der Mark, P.; Ayres, D.L.; Darling, A.; Höhna, S.; Larget, B.; Liu, L.; Suchard, M.A.; Huelsenbeck, J.P. MrBayes 3.2: Efficient bayesian phylogenetic inference and model choice across a large model space. Syst. Biol. 2012, 61, 539–542. [Google Scholar] [CrossRef] [PubMed]
- Yu, G. Using ggtree to visualize data on tree-like structures. Curr. Protoc. Bioinform. 2020, 69, e96. [Google Scholar] [CrossRef]
- Miller, P.M. V-8 juice agar as a general-purpose medium for fungal and bacteria. Phytopathology 1955, 45, 461–462. [Google Scholar]
- Dick, M.A.; Williams, N.M.; Bader, M.K.-F.; Gardner, J.F.; Bulman, L.S. Pathogenicity of Phytophthora pluvialis on Pinus radiata and its relation with red needle cast disease in New Zealand. N. Z. J. For. Sci. 2014, 44, 6. [Google Scholar] [CrossRef]
- De Cock, A.W.; Ilieva, E.; Lévesque, C.A. Gene flow analysis of Phytophthora porri reveals a new species: Phytophthora brassicae sp. nov. Eur. J. Plant Pathol. 2002, 108, 51–62. [Google Scholar]
- Donahoo, R.; Blomquist, C.L.; Thomas, S.L.; Moulton, J.K.; Cooke, D.E.; Lamour, K.H. Phytophthora foliorum sp. nov., a new species causing leaf blight of azalea. Mycol. Res. 2006, 110, 1309–1322. [Google Scholar] [CrossRef]
- Thomas, J.; Nechwatal, J.; Cooke, D.E.; Hartmann, G.; Blaschke, M.; OßWALD, W.F.; Duncan, J.M.; Delatour, C. Phytophthora pseudosyringae sp. nov., a new species causing root and collar rot of deciduous tree species in Europe. Mycol. Res. 2003, 107, 772–789. [Google Scholar]
- Reeser, P.W.; Hansen, E.M.; Sutton, W. Phytophthora siskiyouensis, a new species from soil, water, myrtlewood (Umbellularia californica) and tanoak (Lithocarpus densiflorus) in southwestern Oregon. Mycologia 2007, 99, 639–643. [Google Scholar] [CrossRef]
- Hall, G. Peronospora hyoscyami f. sp. tabacina. Mycopathologia 1989, 106, 191–193. [Google Scholar]
- Thines, M.; Choi, Y.-J. Evolution, diversity, and taxonomy of the Peronosporaceae, with focus on the genus Peronospora. Phytopathology 2016, 106, 6–18. [Google Scholar] [CrossRef] [PubMed]
- Jung, T.; Scanu, B.; Bakonyi, J.; Seress, D.; Kovács, G.; Durán, A.; Von Stowasser, E.S.; Schena, L.; Mosca, S.; Thu, P. Nothophytophthora gen. nov., a new sister genus of Phytophthora from natural and semi-natural ecosystems. Pers. Mol. Phylogeny Evol. Fungi 2017, 39, 143. [Google Scholar] [CrossRef] [PubMed]
- Sun, J.; Gao, Z.; Zhang, X.; Zou, X.; Cao, L.; Wang, J. Transcriptome analysis of Phytophthora litchii reveals pathogenicity arsenals and confirms taxonomic status. PLoS ONE 2017, 12, e0178245. [Google Scholar] [CrossRef] [PubMed]
- Ye, W.; Wang, Y.; Shen, D.; Li, D.; Pu, T.; Jiang, Z.; Zhang, Z.; Zheng, X.; Tyler, B.M.; Wang, Y. Sequencing of the litchi downy blight pathogen reveals it is a Phytophthora species with downy mildew-like characteristics. Mol. Plant-Microbe Interact. 2016, 29, 573–583. [Google Scholar] [CrossRef]
- Ann, P.J.; Ko, W. Oospore germination of Peronophythora litchii. Mycologia 1980, 72, 611–614. [Google Scholar] [CrossRef]
- Ho, H.; Jiayun, L.; Longyin, G. Observations on asexual reproduction by Peronophythora litchii. Mycologia 1984, 76, 745–747. [Google Scholar] [CrossRef]
- Ko, W.; Chang, H.; Su, H.; Chen, C.; Leu, L. Peronophythoraceae, a new family of Peronosporales. Mycologia 1978, 70, 380–384. [Google Scholar] [CrossRef]
- Michelmore, R.W.; Ilott, T.; Hulbert, S.; Farrara, B. The downy mildews. In Advances in Plant Pathology; Elsevier: Amsterdam, The Netherlands, 1988; Volume 6, pp. 53–79. [Google Scholar]
- Göker, M.; Voglmayr, H.; Riethmüller, A.; Oberwinkler, F. How do obligate parasites evolve? A multi-gene phylogenetic analysis of downy mildews. Fungal Genet. Biol. 2007, 44, 105–122. [Google Scholar] [CrossRef]
- May, K.J.; Ristaino, J.B. Identity of the mtDNA haplotype(s) of Phytophthora infestans in historical specimens from the Irish Potato Famine. Mycol. Res. 2004, 108, 471–479. [Google Scholar] [CrossRef]
- Anderegg, W.R.L.; Trugman, A.T.; Badgley, G.; Anderson, C.M.; Bartuska, A.; Ciais, P.; Cullenward, D.; Field, C.B.; Freeman, J.; Goetz, S.J.; et al. Climate-driven risks to the climate mitigation potential of forests. Science 2020, 368, eaaz7005. [Google Scholar] [CrossRef] [PubMed]
- Cavicchioli, R.; Ripple, W.J.; Timmis, K.N.; Azam, F.; Bakken, L.R.; Baylis, M.; Behrenfeld, M.J.; Boetius, A.; Boyd, P.W.; Classen, A.T.; et al. Scientists’ warning to humanity: Microorganisms and climate change. Nat. Rev. Microbiol. 2019, 17, 569–586. [Google Scholar] [CrossRef] [PubMed]
- Potter, C.; Urquhart, J. Tree disease and pest epidemics in the Anthropocene: A review of the drivers, impacts and policy responses in the UK. For. Policy Econ. 2017, 79, 61–68. [Google Scholar] [CrossRef]
- Brar, S.; Tabima, J.F.; McDougal, R.L.; Dupont, P.-Y.; Feau, N.; Hamelin, R.C.; Panda, P.; LeBoldus, J.M.; Grünwald, N.J.; Hansen, E.M.; et al. Genetic diversity of Phytophthora pluvialis, a pathogen of conifers, in New Zealand and the west coast of the United States of America. Plant Pathol. 2018, 67, 1131–1139. [Google Scholar] [CrossRef]
- Tabima, J.F.; Gonen, L.; Gómez-Gallego, M.; Panda, P.; Grünwald, N.J.; Hansen, E.M.; McDougal, R.; LeBoldus, J.M.; Williams, N.M. Molecular phylogenomics and population structure of Phytophthora pluvialis. Phytopathologym 2021, 111, 108–115. [Google Scholar] [CrossRef]
- Studholme, D.J.; Panda, P.; Sanfuentes Von Stowasser, E.; González, M.; Hill, R.; Sambles, C.; Grant, M.; Williams, N.M.; McDougal, R.L. Genome sequencing of oomycete isolates from Chile supports the New Zealand origin of Phytophthora kernoviae and makes available the first Nothophytophthora sp. genome. Mol. Plant Pathol. 2019, 20, 423–431. [Google Scholar] [CrossRef]

| NZFS No. | Host Substrate | Location | Year Sampled | GenBank Accession |
|---|---|---|---|---|
| 3603 1,2,3,4 | Podocarpus totara | Hampton Forest, Gisborne | 2011 | - |
| 3642 1,2,3,4 | Podocarpus totara | Hampton Forest, Gisborne | 2011 | LGSN00000000 |
| 3645 1,2,3,4 | Podocarpus totara | Hampton Forest, Gisborne | 2011 | - |
| 3702 1,2,3 | Podocarpus totara | Mata Forest, Gisborne | 2012 | - |
| 3727 1,2,3,4 | Podocarpus totara | Pipiwai Forest, Northland | 2012 | LGSO00000000 |
| 3768 1,4 | Podocarpus totara | Hampton Forest, Gisborne | 2011 | - |
| 4074 1,4 | Podocarpus totara | Mata Forest, Gisborne | 2014 | - |
| 4473 1,2,3 | Podocarpus totara | Otunui Forest, Taranaki | 2017 | - |
| 4525 1 | Podocarpus totara | Crystals Forest, Hawkes Bay | 2017 | - |
| 4526 1,2,3 | Podocarpus totara | Kinleith Forest, Bay of Plenty | 2017 | - |
Publisher’s Note: MDPI stays neutral with regard to jurisdictional claims in published maps and institutional affiliations. |
© 2022 by the authors. Licensee MDPI, Basel, Switzerland. This article is an open access article distributed under the terms and conditions of the Creative Commons Attribution (CC BY) license (https://creativecommons.org/licenses/by/4.0/).
Share and Cite
Dobbie, K.; Scott, P.; Taylor, P.; Panda, P.; Sen, D.; Dick, M.; McDougal, R. Phytophthora podocarpi sp. nov. from Diseased Needles and Shoots of Podocarpus in New Zealand. Forests 2022, 13, 214. https://doi.org/10.3390/f13020214
Dobbie K, Scott P, Taylor P, Panda P, Sen D, Dick M, McDougal R. Phytophthora podocarpi sp. nov. from Diseased Needles and Shoots of Podocarpus in New Zealand. Forests. 2022; 13(2):214. https://doi.org/10.3390/f13020214
Chicago/Turabian StyleDobbie, Kiryn, Peter Scott, Pam Taylor, Preeti Panda, Diya Sen, Margaret Dick, and Rebecca McDougal. 2022. "Phytophthora podocarpi sp. nov. from Diseased Needles and Shoots of Podocarpus in New Zealand" Forests 13, no. 2: 214. https://doi.org/10.3390/f13020214
APA StyleDobbie, K., Scott, P., Taylor, P., Panda, P., Sen, D., Dick, M., & McDougal, R. (2022). Phytophthora podocarpi sp. nov. from Diseased Needles and Shoots of Podocarpus in New Zealand. Forests, 13(2), 214. https://doi.org/10.3390/f13020214

